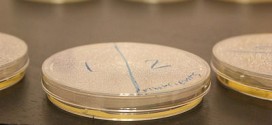
University to review sperm bank mix-up

Justin Bieber avoids his many recent troubles in Los Angeles involving the police, Selena Gomez, and drug rumors by escaping to Cuba. The highly popular 19-year-old Canadian pop star said on the Instagram social network today “I’m in Cuba and I love Cubans.” He did not say where exactly he is in Cuba nor how long he would be staying …
Read More »News
Texting while walking dangerous : study confirms
Texting can make you drive like a drunk. Now a new study shows that texting can also make you walk like a robot. Researchers found that healthy people who read or send texts while hoofing it show subtle but potentially hazardous changes to their gait. As pedestrians busily tap and flick, they swerve more, walk more slowly and move their …
Read More »Richard Sherman’s jersey among best selling
Much has been said and written since Seahawks’ cornerback Richard Sherman launched his epic rant on live TV after the NFC championship game on Sunday. Most of it has been negative, and a few have said that Sherman’s word were enough to make people pull for the Denver Broncos in the Super Bowl. But Sherman turns out to be one …
Read More »University to review sperm bank mix-up : Report
The University of Utah now admits it bears more responsibility than previously thought in a sperm switch case that rocked a family from Texas. The family discovered that a convicted felon, working in the lab that handled sperm samples, actually fathered their daughter. University of Utah Healthcare says it takes full responsibility for a sperm sample switch that resulted in …
Read More »Rick Ross buys evan Holyfield mansion in Georgia
What’s white-ish taupe, formerly owned by Evander Holyfield, 44,234-square-feet, 109 rooms, and has two swimming pools — one of which is the largest in the entire United States? Rick Ross’s new house! (Also, the new student center at your alma mater.)
Read More »Shakira house price cut : $2 Million Off Miami Beach Mansion
The Voice coach Shakira is so serious about unloading her fancy Miami Beach mansion that she discounted the prize by $2 MILLION! The superstar pop singer has made it known she now would be satisfied with $13 million. She put the Zen-decorated crib on the market in the summer for $15 million, but I’m told by a real estate snitch …
Read More »Titanic Hoax Solved By DNA : Canadian ‘heiress’ is exposed as fraud
A Canadian woman who claimed to be the daughter of a wealthy entrepreneur, who had perished in the Titanic tragedy with his family, has been proved to be a fraud in DNA tests, according to reports. Helen Kramer emerged in 1940, calling herself Loraine Allison, a two-year-old toddler who was with her parents Hudson and Bess Allison, and seven-month-old brother …
Read More »Halliburton manager sentenced in oil spill (Video)
A former Halliburton manager was sentenced him to one year of probation for destroying evidence in the aftermath of BP’s 2010 oil spill in the Gulf of Mexico. Anthony Badalamenti had faced a maximum of one year in prison at his sentencing by U.S. District Judge Jay Zainey. Badalamenti pleaded guilty in October to one misdemeanor count of destruction of …
Read More »Pollution from China Reaches U.S., Study Finds
According to a new report from the US National Academy of Sciences, polluting industries in China are having a big role in increasing pollution in Los Angeles and other states of US. As there cannot be any national boundaries to curb pollution, smog from China is continuously drifting into the United States across the Pacific Ocean. It may sound strange, …
Read More »Jaden Newman puts up 63 points : 9-year-old stars on varsity hoops team
Her name is Jaden Newman and this video shows her dominating a high school varsity basketball team. A stand out player in high school basketball might not be rare, but as you can probably tell, Newman isn’t 17 or 18 like most of her opponents presumably are, she is a nine-year-old currently in the 4th grade. And this doesn’t seem …
Read More »Scientists accidentally capture ball lightning (Video)
Stories of mysterious lightning balls appearing during storms go back hundreds of years. Mostly people just chalked this up to “yeah, and I’ve seen a UFO too, bro”; but now, for the first time ever, Chinese scientists have actually observed ball lightning in the wild.
Read More » Canada Journal – News of the World Articles and videos to bring you the biggest Canadian news stories from across the country every day
Canada Journal – News of the World Articles and videos to bring you the biggest Canadian news stories from across the country every day